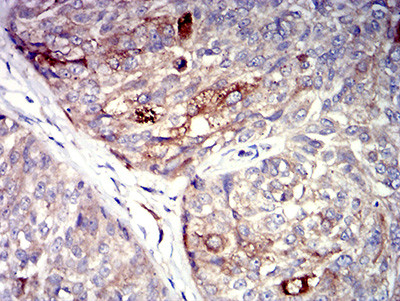
P2Y4 Antibody in Immunohistochemistry (Paraffin) (IHC (P))

Search
Invitrogen
P2Y4 Monoclonal Antibody (3B4C11)
{{$productOrderCtrl.translations['antibody.pdp.commerceCard.promotion.promotions']}}
{{$productOrderCtrl.translations['antibody.pdp.commerceCard.promotion.viewpromo']}}
{{$productOrderCtrl.translations['antibody.pdp.commerceCard.promotion.promocode']}}: {{promo.promoCode}} {{promo.promoTitle}} {{promo.promoDescription}}. {{$productOrderCtrl.translations['antibody.pdp.commerceCard.promotion.learnmore']}}
产品信息
MA5-31822
种属反应
宿主/亚型
分类
类型
克隆号
抗原
偶联物
形式
浓度
规格
纯化类型
保存液
内含物
保存条件
运输条件
RRID
产品详细信息
Amino acid sequence of the immunogen is proprietary. This antibody has been tested in indirect ELISA.
靶标信息
Receptor for UTP and UDP coupled to G-proteins that activate a phosphatidylinositol-calcium second messenger system. Not activated by ATP or ADP.
仅用于科研。不用于诊断过程。未经明确授权不得转售。
篇参考文献 (0)
生物信息学
蛋白别名: P2P; P2Y purinoceptor 4; P2Y4; P2YR4; pyrimidinergic receptor P2Y, G-protein coupled, 4; RP13-26D14.5; UNR; Uridine nucleotide receptor
基因别名: NRU; P2P; P2RY4; P2Y4; UNR
UniProt ID: (Human) P51582
Entrez Gene ID: (Human) 5030